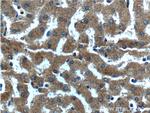
CXCL14 Antibody in Immunohistochemistry (Paraffin) (IHC (P))

Search
Proteintech
CXCL14 Polyclonal Antibody
{{$productOrderCtrl.translations['antibody.pdp.commerceCard.promotion.promotions']}}
{{$productOrderCtrl.translations['antibody.pdp.commerceCard.promotion.viewpromo']}}
{{$productOrderCtrl.translations['antibody.pdp.commerceCard.promotion.promocode']}}: {{promo.promoCode}} {{promo.promoTitle}} {{promo.promoDescription}}. {{$productOrderCtrl.translations['antibody.pdp.commerceCard.promotion.learnmore']}}
产品信息
10468-1-AP
种属反应
已发表种属
宿主/亚型
分类
类型
抗原
偶联物
形式
浓度
规格
纯化类型
保存液
内含物
保存条件
运输条件
产品详细信息
Immunogen sequence: MSLLPRRAP PVSMRLLAAA LLLLLLALYT ARVDGSKCKC SRKGPKIRYS DVKKLEMKPK YPHCEEKMVI ITTKSVSRYR GQEHCLHPKL QSTKRFIKWY NAWNEKRRVY EE (1-111 aa encoded by BC003513)
靶标信息
This gene belongs to the cytokine gene family which encode secreted proteins involved in immunoregulatory and inflammatory processes. The protein encoded by this gene is structurally related to the CXC (Cys-X-Cys) subfamily of cytokines. Members of this subfamily are characterized by two cysteines separated by a single amino acid. This cytokine displays chemotactic activity for monocytes but not for lymphocytes, dendritic cells, neutrophils or macrophages. It has been implicated that this cytokine is involved in the homeostasis of monocyte-derived macrophages rather than in inflammation.
仅用于科研。不用于诊断过程。未经明确授权不得转售。
生物信息学
蛋白别名: bolekine; breast and kidney; C Cmotif chemokine; C X C motif chemokine; C-X-C motif chemokine 14; CC motif chemokine; CCmotif chemokine; chemokine (C-X-C motif) ligand 14; Chemokine BRAK; CXC; CXC chemokine; CXC chemokine in breast and kidney; CXC motif chemokine; CXCL; MGC10687; MIP-2 gamma; MIP-2G; small inducible cytokine subfamily B (Cys-X-Cys), member 14 (BRAK); Small-inducible cytokine B14; tumor-suppressing chemokine; unnamed protein product
基因别名: BMAC; BRAK; CXCL14; KEC; KS1; MIP-2g; MIP2G; NJAC; PSEC0212; SCYB14; UNQ240/PRO273
UniProt ID: (Human) O95715
Entrez Gene ID: (Human) 9547